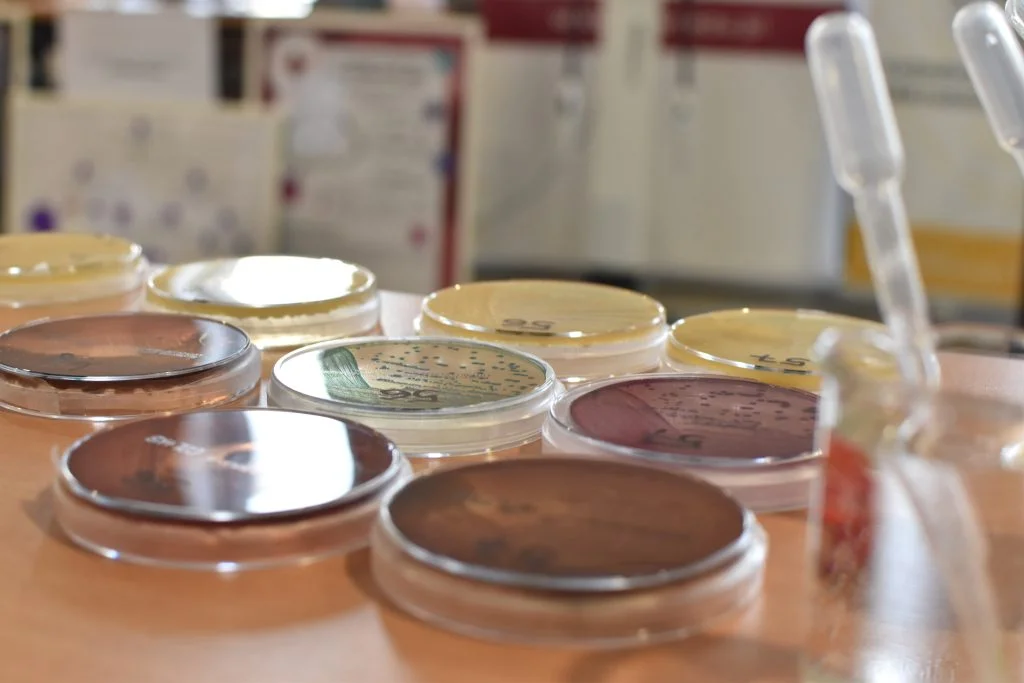

Polska sięga gwiazd! Spotkanie Kół Naukowych, studentów i doktorantów UWr z dr. inż. Sławoszem Uznańskim-Wiśniewskim
Polski astronauta odwiedził Wrocław będący siódmym przystankiem trasy technologiczno-naukowej „IGNIS – Polska sięga gwiazd„. Spotkanie odbyło się 12 listopada 2025 r., a jego gospodarzem był Uniwersytet Medyczny im. Piastów Śląskich. Udział w nim wzięli studenci i doktoranci wrocławskich uczelni – pięćdziesięcioro z nich reprezentowało Uniwersytet Wrocławski.
Opowieści z orbity
Głównym punktem pierwszej części wydarzenia był wykład dr. inż. Sławosza Uznańskiego-Wiśniewskiego, który poprzedzony został krótkimi wystąpieniami gospodarzy i organizatorów spotkania. W swojej prelekcji astronauta opowiadał zarówno o przebiegu Misji Axiom-4, jak i aspektach fizjologiczno-medycznych związanych z przebywaniem na orbicie. Dr inż. Sławosz Uznański-Wiśniewski odpowiedział również na liczne pytania publiczności, między innymi zadane przez naszych reprezentatów.
„Czasem się tak mówi, że podróże w kosmos stanowią pewną historyczną kontynuację odkryć geograficznych, nowych mórz, lądów. Czy dawne doświadczenia tych odkrywców, choćby na przykładzie badań polarnych, są w jakimś stopniu wykorzystywane w planowaniu misji kosmicznych pod względem izolacji czy trudnych warunków?” – zapytał p. Kacper, student z Wydziału Nauk o Ziemii i Kształtowania Środowiska. W odpowiedzi astronauta opowiedział o swoich prywatnych doświadczeniach z ekspedycji eksploracyjnych w wysokich górach i podobieństwach tych doświadczeń do lotu w kosmos. Podkreślił, że w obydwu tych przypadkach ważne jest wybranie celu, rozpoznanie terenu, poznanie mocnych i słabych stron członków załogi, zaplanowanie trasy, ale jednocześnie podejmowanie decyzji w czasie rzeczywistym, nierzadko przy wsparciu zespołu z zewnątrz. Astronauta dodał, że w naturze ludzkiej leży chęć poznania i odpowiedzenia na pytania, na które odpowiedzi jeszcze nie znamy – i na Ziemi, i poza nią.
Szansa na zadanie ostatniego pytania przypadła również naszej reprezentantce. Doktorantka UWr p. Weronika z Kolegium Doktorskiego Nauk Biologicznych zapytała „Czy w trakcie misji wydarzyła się jakaś nieoczekiwana sytuacja, która zaskoczyła załogę? Jak sobie z nią poradziliście?”. Dr inż. Sławosz Uznański-Wiśniewski podkreślił, że „niespodziewane” jest wpisane w zawód astronauty, a najważniejszą cechą jest umiejętność radzenia sobie w nowych sytuacjach i podejmowania decyzji pod presją. Przyznał, że nieoczekiwanych sytuacji było bardzo wiele, a jedną z tych, która utkwiła mu w pamięci, był problem z instalacją jednego z eksperymentów. Astronauta podzielił się nie tylko tą historią, ale także swoimi emocjami i strategią jaką obrał, by przezwyciężyć napotkany problem.
Eksperymenty w kosmosie
W trakcie spotkania odbyły się prezentacje dwóch spośród wielu eksperymentów, które astronauta współprowadził na Międzynarodowej Stacji Kosmicznej. Dr inż. Weronika Urbańska (Politechnika Wrocławska) opowiedziała o projekcie Space Volcanic Algae, który polegał na zbadaniu procesu adaptacji mikroglonów z ekstremalnych środowisk wulkanicznych i ich funkcjonowania w warunkach mikrograwitacji i promieniowania kosmicznego. Następnie mgr Konrad Opaliński (Uniwersytet Zielonogórski) zaprezentował projekt AstroMentalHealth, w ramach którego sprawdzano jak izolacja w trakcie misji kosmicznej wpływa na dobrostan psychiczny astronautów. Co ciekawe, nad przygotowaniem tego projektu pracował także prof. dr hab. Dariusz Galasiński z Zakładu Sztuk Audiowizualnych w Instytucie Dziennikarstwa i Komunikacji Społecznej. Tę część wydarzenia zakończyła debata z udziałem zaproszonych gości, poprowadzona przez p. Miłosza Wałkowieckiego z Radia RAM.
Zapis z części wykładowej spotkania dostępny jest na platformie YouTube: https://www.youtube.com/watch?v=aoNgqcu2w74
Spotkania Kół naukowych z astronautą
Po części wykładowej przyszedł czas na spotkania dr. inż. Sławosza Uznańskiego-Wiśniewskiego z kołami naukowymi reprezentującymi wszystkie uczelnie Wrocławia. Jako jedni z pierwszych o prowadzonych przez siebie działaniach opowiedzieli przedstawiciele trzech kół naukowych z Uniwersytetu Wrocławskiego. Byli to: p. Dominika Jurkowska i p. Maja Kołkowska z Koła Naukowego Chemików „Jeż”, p. Paulina Ficke i p. Weronika Gabrylewicz z Międzywydziałowego Studenckiego Koła Naukowego Mikrobiologów oraz p. Julia Stasiukiewicz i p. Adrian Keklak ze Studenckiego Koła Naukowego Geologów.

Wszystkie Koła przygotowały krótką prezentację swoich działań – były to między innymi ekspresowe eksperymenty, quizy czy przykłady prowadzonych badań i działań popularyzujących naukę. Pomimo napiętego programu wydarzenia, nasi reprezentanci mogli opowiedzieć o swoich kołach naukowych astronaucie i razem z nim stanąć do wspólnego zdjęcia. Działalność naszych studentów przykuła też uwagę innych uczestników wydarzenia, którzy z zainteresowaniem podchodzili do stoiska Kół Naukowych Uniwersytetu Wrocławskiego. Była to również szansa, aby wymienić się doświadczeniami, inicjatywami i wzbudzić pomysły na wspólne projekty z kołami naukowymi innych uczelni.
Reprezentanci Uniwersytetu Wrocławskiego udzielali również wywiadów dla mediów obecnych na spotkaniu – wywiady z nimi można usłyszeć m.in. w Radiu Rodzina (https://www.radiorodzina.pl/2025/11/12/slawosz-uznanski-wisniewski-spotkal-sie-z-dolnoslaskimi-uczniami-i-studentami/), Radiu Wrocław (https://www.radiowroclaw.pl/articles/view/155765/Dr-Slawosz-Uznanski-Wisniewski-odwiedzil-Wroclaw-Astronauta-spotkal-sie-ze-studentami) czy TVP Wrocław (https://wroclaw.tvp.pl/89979177/uznanski-wisniewski-licze-na-rozwoj-w-polsce-medycyny-kosmicznej-i-badan-medycznych-na-orbicie).
tekst i zdjęcia: A. Brzostowska (BWASD)